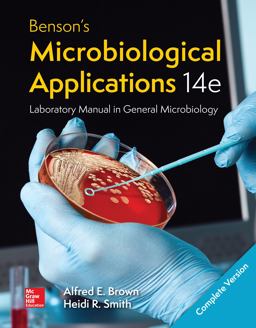
Benson's Microbiological Applications Laboratory Manual--Complete Version Benson's Microbiological Applications Laboratory Manual--Complete Version

More from this Author
Found 29 books by Heidi Smith

Benson's Microbiological Applications Laboratory Manual
by Heidi Smith, Alfred E. Brown

The Uncommon Book of Prayer
by Heidi Smith, Chelsea Granger (Illustrator)

Loose Leaf for Microbiology Fundamentals: a Clinical Approach
by Marjorie Kelly Cowan, Heidi Smith, Jennifer Lusk

Loose Leaf for Microbiology Fundamentals: a Clinical Approach
by Marjorie Kelly Cowan, Heidi Smith

Microbiology
by M. Kelly Cowan, Heidi Smith

Microbiology Fundamentals
by M. Kelly Cowan, Heidi Smith

Microbiology
by Marjorie Kelly Cowan, Heidi Smith

Loose Leaf for Microbiology: a Systems Approach
by Marjorie Kelly Cowan, Heidi Smith

Microbiology Fundamentals
by Marjorie Kelly Cowan, Heidi Smith, Jennifer Lusk

How to Pass Numerical Reasoning Tests
by Heidi Smith

Loose Leaf for Benson's Microbiological Applications Lab Manual
by Alfred E. Brown, Heidi Smith

LooseLeaf Benson's Microbiological Applications Laboratory Manual--Concise Version
by Alfred E. Brown, Heidi Smith

Microbiology Fundamentals
by M. Kelly Cowan, Heidi Smith, Jennifer Lusk

Benson's Microbiological Applications Complete Version
by Alfred E. Brown, Heidi Smith

Connect Access Card for Microbiology Fundamentals: a Clinical Approach
by Marjorie Kelly Cowan, Heidi Smith

Loose Leaf for Microbiology: a Systems Approach
by Marjorie Kelly Cowan, Heidi Smith

Benson's Microbiological Applications, Laboratory Manual in General Microbiology, Short Version
by Alfred E. Brown, Heidi Smith

ISE Microbiology Fundamentals: a Clinical Approach
by Marjorie Kelly Cowan, Heidi Smith

Microbiology Fundamentals
by M. Kelly Cowan, Heidi Smith

How to Pass Numerical Reasoning Tests
by Heidi Smith
Benson's Microbiological Applications Laboratory Manual--Complete Version
by Alfred E. Brown, Heidi Smith

An Illustrated Tour
by Courtney Parsons (Illustrator), Heidi Smith

Forks in the Road
by Heidi Smith

Microbiology
by M. Kelly Cowan, Heidi Smith

Loose Leaf Version of Benson's Microbiology Applications: Lab Manual in General Microbiology Complete Version
by Alfred Brown, Heidi Smith

After the Bombs-My Berlin
by Heidi Smith

Bensons Microbiological Applications Laboratory Manual in General Microbiology
by Heidi Smith, Alfred E. Brown

Bensons Microbiological Applications Laboratory Manual in General Microbiology
by Heidi Smith, Alfred E. Brown

Microbiology
by Marjorie Kelly Cowan, Heidi Smith